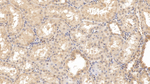
RAB5A Antibody in Immunohistochemistry (Paraffin) (IHC (P))

Search
Invitrogen
RAB5A Monoclonal Antibody (C4)
{{$productOrderCtrl.translations['antibody.pdp.commerceCard.promotion.promotions']}}
{{$productOrderCtrl.translations['antibody.pdp.commerceCard.promotion.viewpromo']}}
{{$productOrderCtrl.translations['antibody.pdp.commerceCard.promotion.promocode']}}: {{promo.promoCode}} {{promo.promoTitle}} {{promo.promoDescription}}. {{$productOrderCtrl.translations['antibody.pdp.commerceCard.promotion.learnmore']}}

Please note: We are reviewing Western blot images included in the antibody testing data in our catalog, including those provided by third parties. Unless expressly labeled or annotated as “raw-unedited”, Western blot images included in the antibody testing data in our catalog may have been edited, optimized or otherwise adjusted for presentation.
产品信息
MA566018
种属反应
宿主/亚型
分类
类型
克隆号
抗原
偶联物
形式
浓度
规格
纯化类型
保存液
内含物
保存条件
运输条件
RRID
靶标信息
RAB5 are among the small GTPases Rab are key regulators of intracellular membrane trafficking, from the formation of transport vesicles to their fusion with membranes. Rabs cycle between an inactive GDP-bound form and an active GTP-bound form that is able to recruit to membranes different sets of downstream effectors directly responsible for vesicle formation, movement, tethering and fusion. RAB5A is required for the fusion of plasma membranes and early endosomes. Contributes to the regulation of filopodia extension. Required for the exosomal release of SDCBP, CD63, PDCD6IP and syndecan. Regulates maturation of apoptotic cell-containing phagosomes, probably downstream of DYN2 and PIK3C3.
仅用于科研。不用于诊断过程。未经明确授权不得转售。
篇参考文献 (0)
生物信息学
蛋白别名: Rab 5; Rab 5A; Ras related protein; Ras-related protein Rab-5A; Small GTP-binding protein rab5
基因别名: RAB5; RAB5A
UniProt ID: (Pig) Q06AU6, (Rat) M0RC99
Entrez Gene ID: (Pig) 100144499, (Rat) 64633




